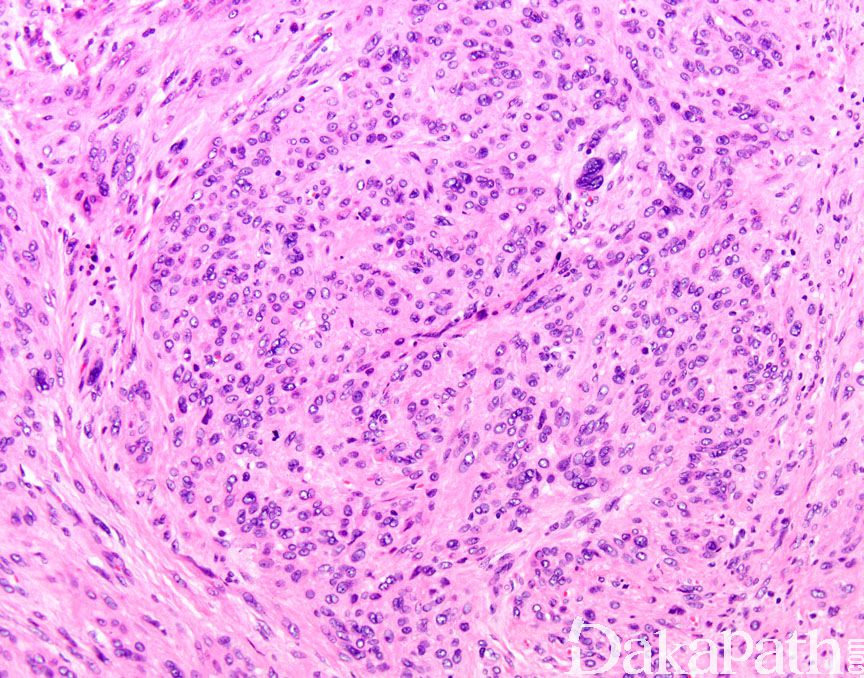

恶性潜能未定的平滑肌肿瘤
Smooth Muscle Tumors of Uncertain Malignant Potential or STUMP
同义词(或曾用名): 不典型平滑肌肿瘤
概述:
指形态学排除平滑肌肉瘤而又不满足平滑肌瘤及其亚型的诊断标准,可能存在恶性潜能的平滑肌肿瘤。
发病部位: 子宫
诊断要点:
平滑肌瘤出现下列情况之一可以诊断为恶性潜能未定的平滑肌肿瘤:
局灶或弥漫中-重度异型,核分裂像 ≤10/10HPF,无凝固性坏死;
无或轻度异型,核分裂像 ≤10/10HPF,有凝固性坏死;
局灶中-重度异型,核分裂像>10/10HPF,无凝固性坏死。
此外,对形态不确定,坏死性质不确定,对核分裂像不确定但具有其他诊断平滑肌肉瘤指征时也可用 STUMP。
鉴别诊断:
← 子宫平滑肌瘤 子宫炎性肌纤维母细胞瘤 →